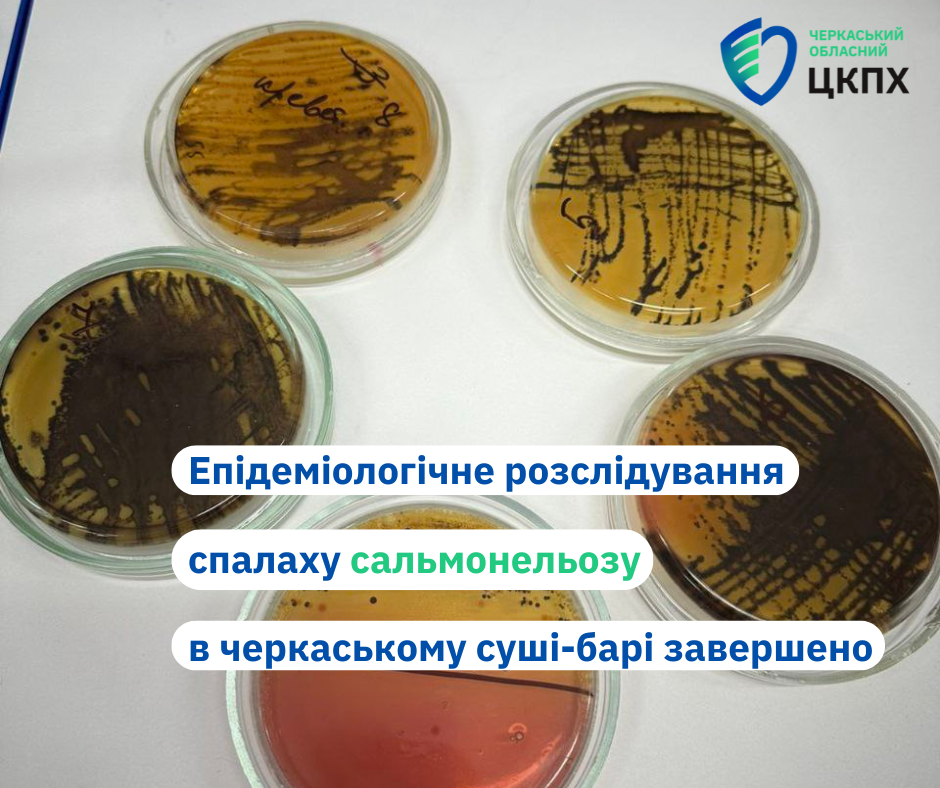

Епідеміологічне розслідування спалаху сальмонельозу в черкаському суші-барі завершено
27 серпня 2024
Державною установою «Черкаський обласний центр контролю та профілактики хвороб МОЗ України» спільно з Головним управлінням Держпродспоживслужби в Черкаській області завершено проведення епідеміологічного розслідування групового захворювання на гостру кишкову інфекцію, що пов’язане із вживанням страв японської кухні, зокрема смажених ролів із різним наповненням (Хот туна, Хот унагі, Хот сяке), виготовлених у черкаському суші-барі «FUGU».
За результатами епідрозслідування встановлено, що потерпілі захворіли після вживання ролів, забруднених Salmonella Typhimurium. Цей збудник було виділено з окремих складових ролів – смаженого вугра, солоного лосося, вареної креветки.
За результатами проведеного інспектування Головним управлінням Держпродспоживслужби в Черкаській області власникам закладу направлені приписи щодо усунення порушень законодавства у сфері безпечності харчових продуктів, винесено адміністративні стягнення у вигляді штрафів, тимчасово призупинялося виробництво та обіг харчових продуктів у суші-барі «FUGU» до завершення розслідування спалаху.
У закладі силами Черкаського обласного ЦКПХ була проведена заключна дезінфекція із наступним лабораторним контролем якості.
Завдяки вжитим протиепідемічним заходам спалах оперативно локалізований та ліквідований.




